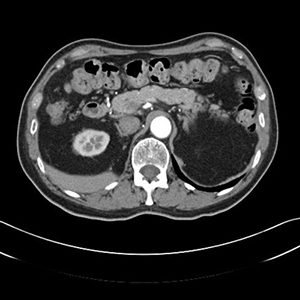

CT abdomen
Aplicabilitate:
Poate identifica chisturi, abcese, infecţii, inflamaţii, tumori sau anevrisme, noduli limfatici, corpuri străine, hemoragii, diverticulită, boală inflamatorie intestinală, apendicită, traumatisme etc. Se vizualizează ficatul, pancreasul, splina, intestinele, sistemul urinar, artera aortă.
- ficatul: tomografia computerizată poate descoperi la acest nivel tumori, hemoragii şi alte afectiuni hepatice;
- pancreasul: poate identifica tumori şi inflamaţii ale pancreasului;
- vezica biliară şi căile biliare principale;
- glandele suprarenale: prin tomografie computerizata se pot identifica tumori sau creşterea în volum a glandelor;
- splina: identificarea leziunilor traumatice ale splinei sau determinarea dimensiunilor acesteia.